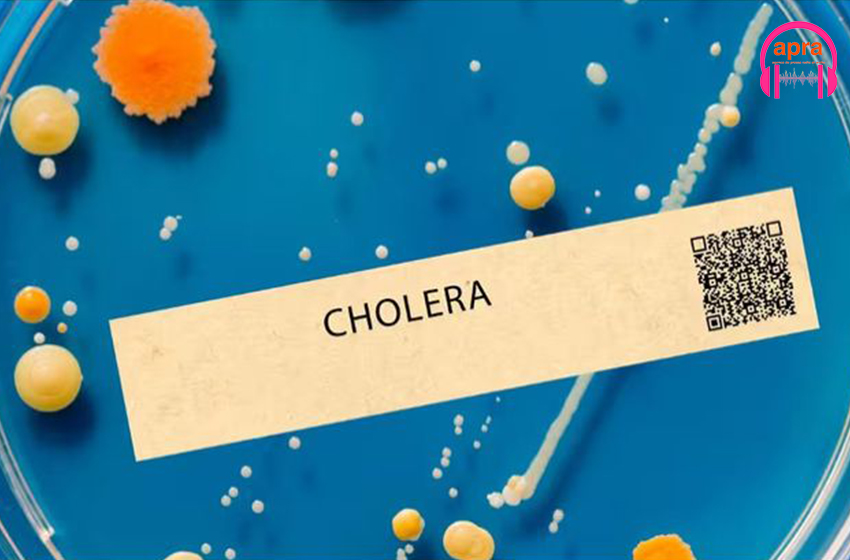
Mayotte /Santé: l’épidémie du choléra s’intensifie.

Actualité africaine/Mélenchon au Sénégal : entente et désaccord s’entremêlent

Actualité africaine/Mélenchon au Sénégal : entente et désaccord s’entremêlent
Un documentaire de Agence Presse Radio
Jean-Luc Mélenchon est un homme politique français. Membre de l’Organisation communiste internationaliste.
Un documentaire de
Agence Presse Radio
Mise en ligne
21 Mai 2024
Réalisation
Agence Presse Radio
Mise en onde & mix
Agence Presse Radio
Illustration
Agence Presse Radio
Production
Agence Presse Radio
Jean-Luc Mélenchon est un homme politique français. Membre de
l’Organisation communiste internationaliste. Président du parti La
France insoumise, il s’est rendu au Sénégal (pays d‘Afrique), pour y
rencontrer les nouveaux hommes au pouvoir dont Ousmane Sonko, le
Premier ministre.
Le leader du parti français d’extrême gauche séjourne dans la capitale
sénégalaise depuis le 14 mai, sur invitation du nouveau Premier
ministre sénégalais. Sonko a profité d’une rencontre avec les
étudiants de l’université Cheikh Anta Diop de Dakar (Ucad) pour s’en
prendre à la France et à son président.
L’hôte des autorités sénégalaises n’a pas manqué de marqué pour ce que
ses amis aient réussi à prendre le pouvoir par les urnes après une
lutte héroïque
Ousmane Sonko connu pour ne pas avoir la langue dans la poche sorti le
sujet qui pourrait être le point de désaccord entre lui et son invité
de Mélenchon, « le mariage pour tous » et les LGBTQ qu’il contre
combattre
Si l’on s’en tient à la publication de nos confrères sénégalais de
Jallale TV, Mélenchon aurait soutenu ce qui suis : « Je suis, si vous
voulez le savoir, hétérosexuel. Mais j'ai pensé que cette liberté
d'amour devait être ouverte à tous ceux qui veulent en bénéficier et
c'est pourquoi je vous dis, les yeux dans les yeux, que j'assume la
position politique que j'ai voulue". Un point d’achoppement qui
pourrait être la divergence entre Sonko et lui.
Texte : SACRE Abel
Audio : Reine KOUAKOU

0 Commentaire(s)